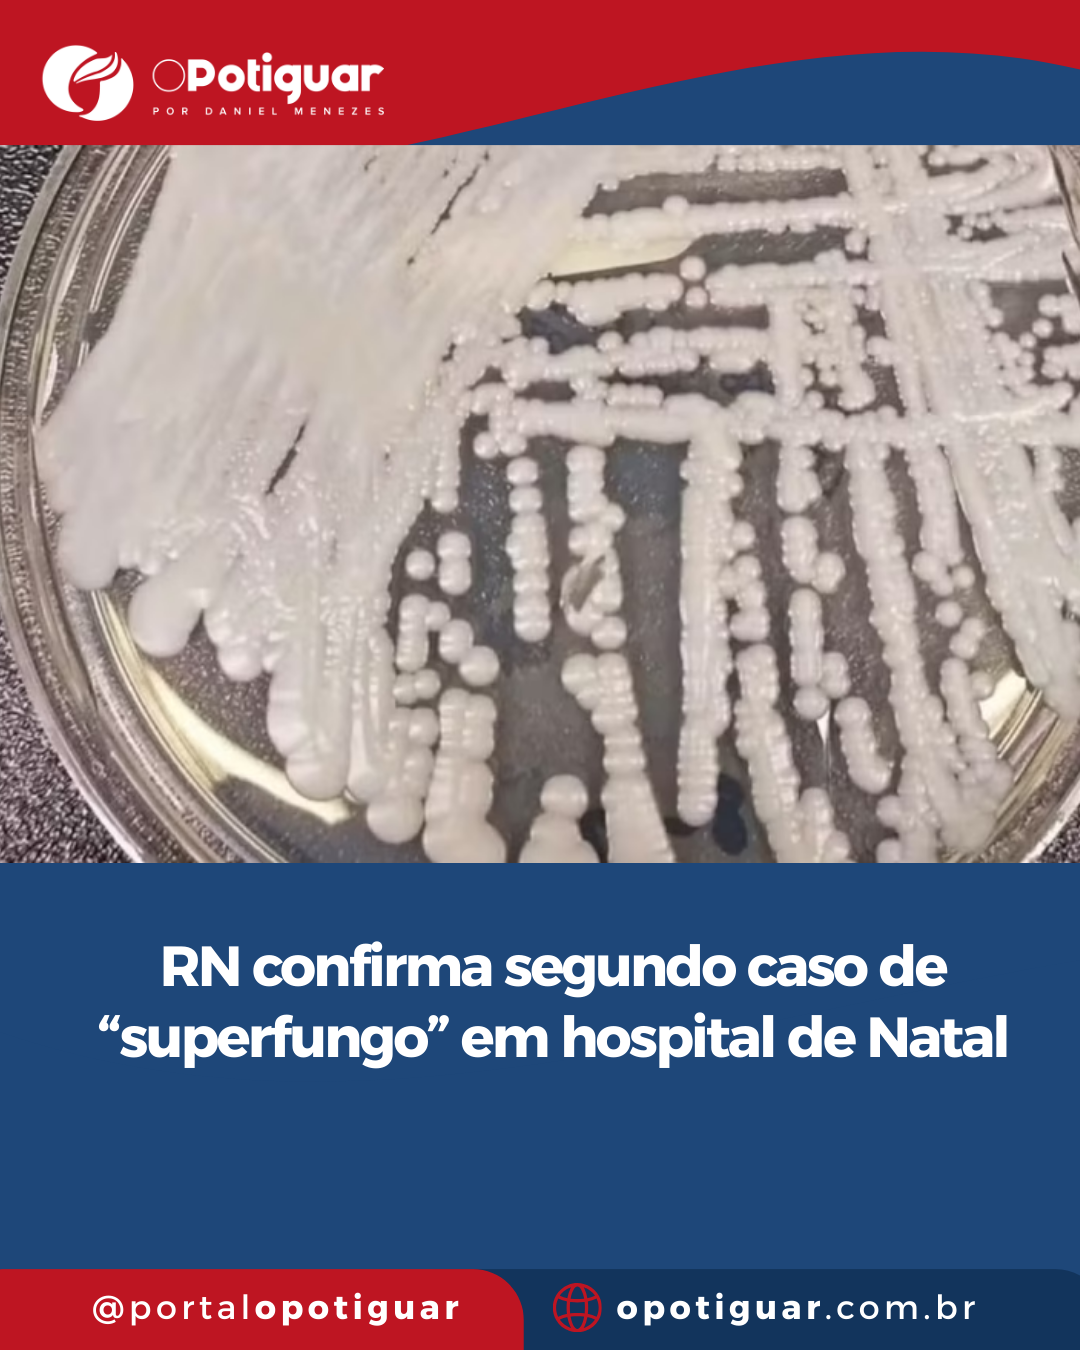

Freire Gomes disse a Bolsonaro que Exército não violaria a Constituição
Da CNN - Em depoimento ao Supremo Tribunal Federal (STF) nesta segunda-feira (19), o general Marco Antônio Freire Gomes, ex-comandante do Exército, afirmou que respondeu ao ex-presiden [...]
Leia mais > [0] Comentários | Deixe seu comentário .